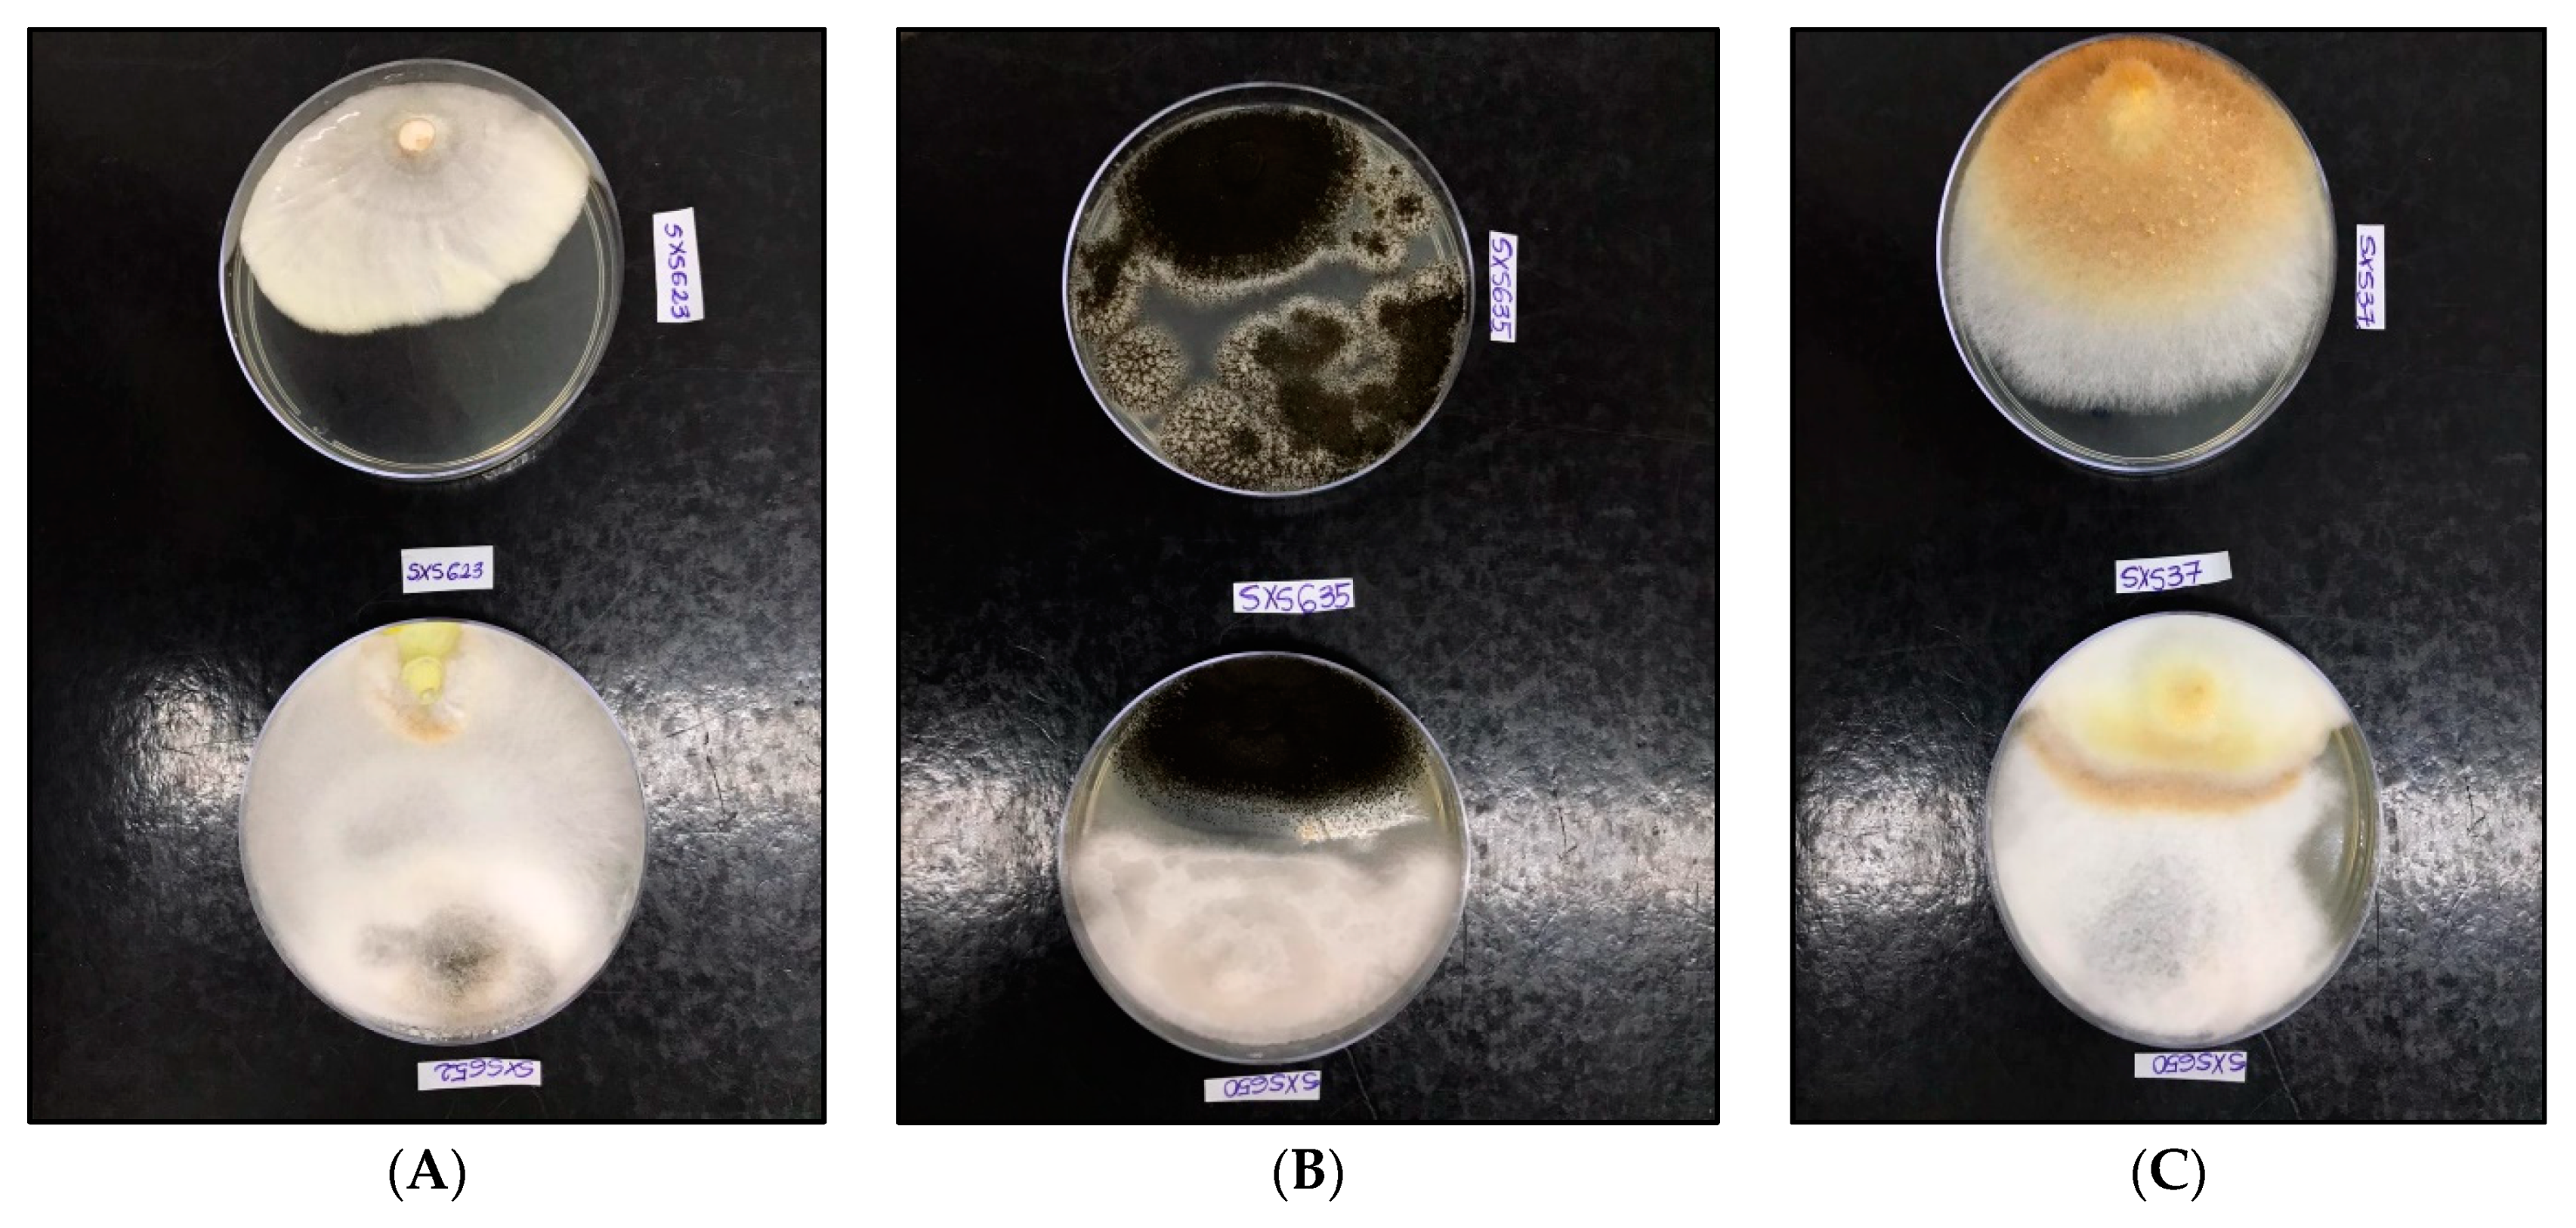
Jof 07 00689 g005

Insights into the Bioprospecting of the Endophytic Fungi of the Medicinal Plant Palicourea rigida Kunth (Rubiaceae): Detailed Biological Activities
Abstract
1. Introduction
2. Materials and Methods
2.1. Study Area and Sampling
2.2. Isolation of Endophytic Mycobiota
2.3. Phenotypic Identification
2.4. Extraction of Active Metabolites
2.5. Determination of Solids Content
2.6. Qualitative and Quantitative Screening of Secondary Metabolites
2.7. Extracellular Degradative Enzymes
2.8. Antioxidant Activity
2.9. Antimicrobial Activity
2.10. Antitumor Activity
2.11. Bioremediative Activity
2.12. Antagonistic Activity
2.13. Toxicity
2.14. Statistical Analysis
3. Results
4. Discussion
5. Conclusions
Author Contributions
Funding
Institutional Review Board Statement
Informed Consent Statement
Acknowledgments
Conflicts of Interest
References
- Coelho, A.J.P.; Magnago, L.F.S.; Matos, F.A.R.; Mota, N.M.; Diniz, É.S.; Meira-Neto, J.A.A. Effects of Anthropogenic Disturbances on Biodiversity and Biomass Stock of Cerrado, the Brazilian Savanna. Biodivers. Conserv. 2020, 29, 3151–3168. [Google Scholar] [CrossRef]
- Mittermeier, R.; Fonseca, G.D.; Rylands, A.B.; Brandon, K. A Brief History of Biodiversity Conservation in Brazil. Conserv. Biol. 2005, 19, 601–607. [Google Scholar] [CrossRef]
- Mussi-Dias, V.; Araújo, A.C.O.; Silveira, S.F.; Rocabado, J.M.A.; Araújo, K.L. Fungos Endofíticos Associados a Plantas Medicinais. Rev. Bras. Plantas Med. 2012, 14, 261–266. [Google Scholar] [CrossRef][Green Version]
- Da Silva, L.E.; Confortin, C.; Swamy, M.K. Antibacterial and Antifungal Plant Metabolites from the Tropical Medicinal Plants. In Bioactive Natural Products for Pharmaceutical Applications; Pal, D., Nayak, A.K., Eds.; Springer International Publishing: Cham, Switzerland, 2021; Volume 140, pp. 263–285. ISBN 978-3-030-54026-5. [Google Scholar]
- Newman, D.J.; Cragg, G.M. Natural Products as Sources of New Drugs over the 30 Years from 1981 to 2010. J. Nat. Prod. 2012, 75, 311–335. [Google Scholar] [CrossRef]
- Rajamanikyam, M.; Vadlapudi, V.; Amanchy, R.; Upadhyayula, S.M. Endophytic Fungi as Novel Resources of Natural Therapeutics. Braz. Arch. Biol. Technol. 2017, 60, 1–26. [Google Scholar] [CrossRef]
- Sun, X.; Guo, L.-D. Endophytic Fungal Diversity: Review of Traditional and Molecular Techniques. Mycology 2012, 3, 65–76. [Google Scholar]
- Vasundhara, M.; Reddy, M.S.; Kumar, A. Secondary Metabolites from Endophytic Fungi and Their Biological Activities. In New and Future Developments in Microbial Biotechnology and Bioengineering; Elsevier: Amsterdam, The Netherlands, 2019; pp. 237–258. ISBN 978-0-444-63504-4. [Google Scholar]
- Gupta, S.; Chaturvedi, P.; Kulkarni, M.G.; Van Staden, J. A Critical Review on Exploiting the Pharmaceutical Potential of Plant Endophytic Fungi. Biotechnol. Adv. 2020, 39, 107462. [Google Scholar] [CrossRef]
- Stierle, A.; Strobel, G.; Stierle, D. Taxol and Taxane Production by Taxomyces andreanae, an Endophytic Fungus of Pacific Yew. Science 1993, 260, 214–216. [Google Scholar] [CrossRef] [PubMed]
- Zheng, R.; Li, S.; Zhang, X.; Zhao, C. Biological Activities of Some New Secondary Metabolites Isolated from Endophytic Fungi: A Review Study. Int. J. Mol. Sci. 2021, 22, 959. [Google Scholar] [CrossRef] [PubMed]
- Mohana Kumara, P.; Zuehlke, S.; Priti, V.; Ramesha, B.T.; Shweta, S.; Ravikanth, G.; Vasudeva, R.; Santhoshkumar, T.R.; Spiteller, M.; Uma Shaanker, R. Fusarium proliferatum, an Endophytic Fungus from Dysoxylum binectariferum Hook.f, Produces Rohitukine, a Chromane Alkaloid Possessing Anti-Cancer Activity. Antonie Van Leeuwenhoek 2012, 101, 323–329. [Google Scholar] [CrossRef]
- Chutulo, E.C.; Chalannavar, R.K. Antimicrobial Activity of Fusarium oxysporium, Endophytic Fungus, Isolated from Psidium guajava L. (White Fruit). Int. J. Pharm. Sci. Res. 2020, 11, 5844–5855. [Google Scholar]
- Phongpaichit, S.; Rungjindamai, N.; Rukachaisirikul, V.; Sakayaroj, J. Antimicrobial Activity in Cultures of Endophytic Fungi Isolated from Garcinia species. FEMS Immunol. Med. Microbiol. 2006, 48, 367–372. [Google Scholar] [CrossRef]
- Chen, L.; Zhang, Q.-Y.; Jia, M.; Ming, Q.-L.; Yue, W.; Rahman, K.; Qin, L.-P.; Han, T. Endophytic Fungi with Antitumor Activities: Their Occurrence and Anticancer Compounds. Crit. Rev. Microbiol. 2016, 42, 454–473. [Google Scholar] [CrossRef]
- Cui, J.; Guo, S.; Xiao, P. Antitumor and Antimicrobial Activities of Endophytic Fungi from Medicinal Parts of Aquilaria sinensis. J. Zhejiang Univ. Sci. B 2011, 12, 385–392. [Google Scholar] [CrossRef]
- Bhagobaty, R.K.; Joshi, S.R. Enzymatic Activity of Fungi Endophytic on Five Medicinal Plant Species of the Pristine Sacred Forests of Meghalaya, India. Biotechnol. Bioprocess Eng. 2012, 17, 33–40. [Google Scholar] [CrossRef]
- Huang, W.-Y.; Cai, Y.-Z.; Xing, J.; Corke, H.; Sun, M. A Potential Antioxidant Resource: Endophytic Fungi from Medicinal Plants. Econ. Bot. 2007, 61, 14–30. [Google Scholar] [CrossRef]
- Nuraini, F.R.; Setyaningsih, R.; Susilowati, A. Antioxidant Activity of Bioactive Compound Produced by Endophytic Fungi Isolated from Endemic Plant of South Kalimantan Mangifera casturi Kosterm. In AIP Conference Proceedings; AIP Publishing LLC: Melville, NY, USA, 2019; p. 080013. [Google Scholar]
- Hu, M.Y.; Zhong, G.H.; Sun, Z.T.; Sh, G.; Liu, H.M.; Liu, X.Q. Insecticidal Activities of Secondary Metabolites of Endophytic Pencillium sp. in Derris elliptica Benth. J. Appl. Entomol. 2005, 129, 413–417. [Google Scholar] [CrossRef]
- Rosa, L.; Tabanca, N.; Techen, N.; Wedge, D.; Bernier, U.; Becnel, J.; Elejalde, N.; Moraes, R. Antifungal and Insecticidal Activity of Endophytic Fungi Associated with the American Medicinal Plant Echinacea purpurea (L.) Moench. (Asteraceae). Planta Med. 2011, 77, 1105–1114. [Google Scholar] [CrossRef]
- Carvalho, C.R.; Gonçalves, V.N.; Pereira, C.B.; Johann, S.; Galliza, I.V.; Alves, T.M.A.; Rabello, A.; Sobral, M.E.G.; Zani, C.L.; Rosa, C.A.; et al. The Diversity, Antimicrobial and Anticancer Activity of Endophytic Fungi Associated with the Medicinal Plant Stryphnodendron adstringens (Mart.) Coville (Fabaceae) from the Brazilian Savannah. Symbiosis 2012, 57, 95–107. [Google Scholar] [CrossRef]
- Vieira, M.L.A.; Johann, S.; Hughes, F.M.; Rosa, C.A.; Rosa, L.H. The Diversity and Antimicrobial Activity of Endophytic Fungi Associated with Medicinal Plant Baccharis trimera (Asteraceae) from the Brazilian Savannah. Can. J. Microbiol. 2014, 60, 847–856. [Google Scholar] [CrossRef]
- Chapla, V.; Zeraik, M.; Cafeu, M.; Silva, G.; Cavalheiro, A.; Bolzani, V.; Young, M.; Pfenning, L.; Araujo, A. Griseofulvin, Diketopiperazines and Cytochalasins from Endophytic Fungi Colletotrichum crassipes and Xylaria sp., and Their Antifungal, Antioxidant and Anticholinesterase Activities. J. Braz. Chem. Soc. 2018, 29, 1707–1713. [Google Scholar] [CrossRef]
- Moraes, M.A.; Santos, B.C.S.; Fabri, R.L.; Scio, E.; Alves, M.S.; Yamamoto, C.H.; Rodarte, M.P.; Del-Vechio-Vieira, G.; Araújo, A.L.; de Sousa, O.V.; et al. Pharmacological Potential of Palicourea rigida Kunth: A Possible Participation of Flavonoid Compounds. J. Med. Plants Res. 2017, 11, 194–206. [Google Scholar] [CrossRef][Green Version]
- Da Rosa, E.A.; Silva, B.C.; da Silva, F.M.; Tanaka, C.M.A.; Peralta, R.M.; de Oliveira, C.M.A.; Kato, L.; Ferreira, H.D.; da Silva, C.C. Flavonoides e Atividade Antioxidante Em Palicourea rigida Kunth, Rubiaceae. Rev. Bras. Farmacogn. 2010, 20, 484–488. [Google Scholar] [CrossRef]
- Pinheiro, R.P.; Moraes, M.A.; Santos, B.C.S.; Fabri, R.L.; Del-Vechio-Vieira, G.; Yamamoto, C.H.; Araújo, A.L.S.M.; Araújo, A.L.A.; Sousa, O.V. Identification of Compounds from Palicourea rigida Leaves with Topical Anti-Inflammatory Potential Using Experimental Models. Inflammopharmacology 2018, 26, 1005–1016. [Google Scholar] [CrossRef] [PubMed]
- Barreto, N.M., Jr.; Angelini, R. Mapeamento Topográfico e Delimitação Fitofisionômica Da Área Natural Do Campus Da UEG (Anápolis) Mostra de Iniciação Científica da Universidade Estadual de Goiás; UEG: Anápolis, Brazil, 2003. [Google Scholar]
- Cardoso, M.R.D.; Marcuzzo, F.F.N.; Barros, J.R. Classificação Climática de Köppen-Geiger Para o Estado de Goiás e o Distrito Federal|Cardoso|ACTA GEOGRÁFICA. Acta Geográfica 2014, 8, 40–55. [Google Scholar]
- Rosa, L.H.; Gonçalves, V.N.; Caligiorne, R.B.; Alves, T.M.A.; Rabello, A.; Sales, P.A.; Romanha, A.J.; Sobral, M.E.G.; Rosa, C.A.; Zani, C.L. Leishmanicidal, Trypanocidal, and Cytotoxic Activities of Endophytic Fungi Associated with Bioactive Plants in Brazil. Braz. J. Microbiol. 2010, 41, 420–430. [Google Scholar] [CrossRef] [PubMed]
- Sutton, B.C. The Genus Glomerella and Its Anamorph Colletotrichum. In Colletotrichum: Biology, Pathology and Control; Bailey, J.A., Jeger, M.J., Eds.; CAB International: Wallingford, UK, 1992; pp. 1–26. [Google Scholar]
- Michereff, S.I.; Noronha, M.A.; Rocha Júnior, O.M.; Silva, J.A.; Mizubuti, E.S.G. Variabilidade de isolados de Alternaria brassicicola no Estado de Pernambuco. Fitopatol. Bras. 2003, 28, 656–663. [Google Scholar] [CrossRef]
- Udayanga, D.; Liu, X.Z.; Crous, P.W.; McKenzie, E.H.C.; Chukeatirote, E.; Hyde, K.D. A multilocus phylogenetic evaluation of Diaporthe (Phomopsis). Fungal Divers. 2012, 5, 157–171. [Google Scholar] [CrossRef]
- Udayanga, D.; Castlebury, L.A.; Rossman, A.Y.; Hyde, K.D. Species limits in Diaporthe: Molecular re-assessment of D. citri, D. cytosporella, D. foeniculina and D. rudis. Persoonia 2014, 32, 83–101. [Google Scholar] [CrossRef]
- Raynor, R.W. A Mycological Colour Chart; Commonwealth Mycological Institute: Surrey, England, 1970. [Google Scholar]
- Castellani, A. The Viability of Some Pathogenic Fungi in Sterile Distilled Water. J. Trop. Med. Hyg. 1939, 24, 270–276. [Google Scholar]
- Bagheri, A.A.; Saadatmand, S.; Niknam, V.; Nejadsatari, T.; Babaeizad, V. Effect of Endophytic Fungus, Piriformospora indica, on Growth and Activity of Antioxidant Enzymes of Rice (Oryza sativa L.) Under Salinity Stress. Int. J. Adv. Biol. Biomed. Res. 2013, 1, 1337–1350. [Google Scholar]
- Aly, A.H.; Debbab, A.; Kjer, J.; Proksch, P. Fungal Endophytes from Higher Plants: A Prolific Source of Phytochemicals and Other Bioactive Natural Products. Fungal Divers. 2010, 41, 1–16. [Google Scholar] [CrossRef]
- Devi, N.N.; Prabakaran, J.J.; Wahab, F. Phytochemical Analysis and Enzyme Analysis of Endophytic Fungi from Centella asiatica. Asian Pac. J. Trop. Biomed. 2012, 2, S1280–S1284. [Google Scholar] [CrossRef]
- Ikram, M.; Ali, N.; Jan, G.; Hamayun, M.; Jan, F.G.; Iqbal, A. Novel Antimicrobial and Antioxidative Activity by Endophytic Penicillium roqueforti and Trichoderma reesei Isolated from Solanum surattense. Acta Physiol. Plant. 2019, 41, 164. [Google Scholar] [CrossRef]
- Singleton, V.L.; Rossi, J.A. Colorimetry of Total Phenolics with Phosphomolybdic-Phosphotungstic Acid Reagents. Am. J. Enol. Vitic. 1965, 16, 144–158. [Google Scholar]
- Rolim, A.; Oishi, T.; Maciel, C.P.M.; Zague, V.; Pinto, C.A.S.O.; Kaneko, T.M.; Consiglieri, V.O.; Velasco, M.V.R. Total Flavonoids Quantification from O/W Emulsion with Extract of Brazilian Plants. Int. J. Pharm. 2006, 308, 107–114. [Google Scholar] [CrossRef]
- Pontecorvo, G.; Roper, J.A.; Chemmons, L.M.; Macdonald, K.D.; Bufton, A.W.J. The Genetics of Aspergillus nidulans. In Advances in Genetics; Elsevier: Amsterdam, The Netherlands, 1953; Volume 5, pp. 141–238. ISBN 978-0-12-017605-2. [Google Scholar]
- Hankin, L.; Anagnostakis, S.L. The Use of Solid Media for Detection of Enzyme Production by Fungi. Mycologia 1975, 67, 597. [Google Scholar] [CrossRef]
- Florencio, C.; Couri, S.; Farinas, C.S. Correlation between Agar Plate Screening and Solid-State Fermentation for the Prediction of Cellulase Production by Trichoderma strains. Enzyme Res. 2012, 2012, e793708. [Google Scholar] [CrossRef]
- Zhao, J.; Fu, Y.; Luo, M.; Zu, Y.; Wang, W.; Zhao, C.; Gu, C. Endophytic Fungi from Pigeon pea [Cajanus Cajan (L.) Millsp.] Produce Antioxidant Cajaninstilbene Acid. J. Agric. Food Chem. 2012, 60, 4314–4319. [Google Scholar] [CrossRef]
- Pan, F.; Su, T.-J.; Cai, S.-M.; Wu, W. Fungal Endophyte-Derived Fritillaria unibracteata Var. wabuensis: Diversity, Antioxidant Capacities in Vitro and Relations to Phenolic, Flavonoid or Saponin Compounds. Sci. Rep. 2017, 7, 42008. [Google Scholar] [CrossRef] [PubMed]
- Pulido, R.; Bravo, L.; Saura-Calixto, F. Antioxidant Activity of Dietary Polyphenols As Determined by a Modified Ferric Reducing/Antioxidant Power Assay. J. Agric. Food Chem. 2000, 48, 3396–3402. [Google Scholar] [CrossRef]
- CLSI. Methods for Dilution Antimicrobial Susceptibility Tests f or Bacteria That Grow Aerobically; Approved St Andard, 8th ed.; CLSI Document M07-A8; Clinical and Laboratory Standards Institute: Wayne, PA, USA, 2009. [Google Scholar]
- Lennette, E.H.; American Society for Microbiology (Eds.) Manual of Clinical Microbiology, 4th ed.; American Society for Microbiology: Washington, DC, USA, 1985; ISBN 978-0-914826-65-1. [Google Scholar]
- Henríquez, M.; Vergara, K.; Norambuena, J.; Beiza, A.; Maza, F.; Ubilla, P.; Araya, I.; Chávez, R.; San-Martín, A.; Darias, J.; et al. Diversity of Cultivable Fungi Associated with Antarctic Marine Sponges and Screening for Their Antimicrobial, Antitumoral and Antioxidant Potential. World J. Microbiol. Biotechnol. 2014, 30, 65–76. [Google Scholar] [CrossRef]
- Trigui, F.; Pigeon, P.; Jalleli, K.; Top, S.; Aifa, S.; El Arbi, M. Selection of a Suitable Disc Bioassay for the Screening of Anti-Tumor Molecules. Int. J. Biomed. Sci. 2013, 9, 230–236. [Google Scholar]
- Bibi, S.; Hussain, A.; Hamayun, M.; Rahman, H.; Iqbal, A.; Shah, M.; Irshad, M.; Qasim, M.; Islam, B. Bioremediation of Hexavalent Chromium by Endophytic Fungi; Safe and Improved Production of Lactuca sativa L. Chemosphere 2018, 211, 653–663. [Google Scholar] [CrossRef]
- Mariano, R.L.R. Métodos de Seleção in Vitro Para o Controle Microbiológico de Patógenos de Plantas. Revisão Anu. Patol. Plantas 1993, 1, 369–409. [Google Scholar]
- Badalyan, S.M.; Garibyan, N.G.; Innocenti, G. Antagonistic Activity of Xylotrophic mushrooms against Pathogenic Fungi of Cereals in Dual Culture; Firenze University Press: Adelaide, Australia, 2002; Volume 41, pp. 220–225. [Google Scholar]
- Edgington, L.V.; Knew, K.L.; Barron, G.L. Fungitoxic Spectrum of Benzimidazole Compounds. Phytopathology 1971, 61, 42. [Google Scholar] [CrossRef]
- Molina-Salinas, G.; Said-Fernández, S.; Nuevo, M. A Modified Microplate Cytotoxicity Assay with Brine Shrimp Larvae (Artemia salina). Pharmacologyonline 2006, 3, 633–638. [Google Scholar]
- Svensson, B.-M.; Mathiasson, L.; Mårtensson, L.; Bergström, S. Artemia salina as Test Organism for Assessment of Acute Toxicity of Leachate Water from Landfills. Environ. Monit. Assess. 2005, 102, 309–321. [Google Scholar] [CrossRef]
- Nguta, J.; Mbaria, J.; Gakuya, D.; Gathumbi, P.K.; Kabasa, J.; Kiama, S. Biological Screening of Kenyan Medicinal Plants Using Artemia salina L. (ARTEMIIDAE). Pharmacologyonline 2011, 2, 458–478. [Google Scholar]
- Dame, Z.T.; Silima, B.; Gryzenhout, M.; van Ree, T. Bioactive Compounds from the Endophytic Fungus Fusarium proliferatum. Nat. Prod. Res. 2016, 30, 1301–1304. [Google Scholar] [CrossRef]
- Hofstetter, V.; Buyck, B.; Croll, D.; Viret, O.; Couloux, A.; Gindro, K. What If Esca Disease of Grapevine Were Not a Fungal Disease? Fungal Divers. 2012, 54, 51–67. [Google Scholar] [CrossRef]
- Rivera-Orduña, F.N.; Suarez-Sanchez, R.A.; Flores-Bustamante, Z.R.; Gracida-Rodriguez, J.N.; Flores-Cotera, L.B. Diversity of Endophytic Fungi of Taxus globosa (Mexican Yew). Fungal Divers. 2011, 47, 65–74. [Google Scholar] [CrossRef]
- Tadych, M.; Bergen, M.S.; Johnson-Cicalese, J.; Polashock, J.J.; Vorsa, N.; White, J.F. Endophytic and Pathogenic Fungi of Developing Cranberry Ovaries from Flower to Mature Fruit: Diversity and Succession. Fungal Divers. 2012, 54, 101–116. [Google Scholar] [CrossRef]
- Bailey, J.A.; Jeger, M.J. Colletotrichum: Biology, Pathology and Control; CAB International Press: Wallingford, UK, 1992. [Google Scholar]
- Manamgoda, D.S.; Udayanga, D.; Cai, L.; Chukeatirote, E.; Hyde, K.D. Endophytic Colletotrichum from Tropical Grasses with a New Species C. endophytica. Fungal Divers. 2013, 61, 107–115. [Google Scholar] [CrossRef]
- Farr, D.F.; Rossman, A.Y. Fungal Databases, U.S. National Fungus Collections, ARS, USDA. Available online: https://nt.ars-grin.gov/fungaldatabases/ (accessed on 12 July 2021).
- Tonial, F.; Maia, B.H.L.N.S.; Gomes-Figueiredo, J.A.; Sobottka, A.M.; Bertol, C.D.; Nepel, A.; Savi, D.C.; Vicente, V.A.; Gomes, R.R.; Glienke, C. Influence of Culturing Conditions on Bioprospecting and the Antimicrobial Potential of Endophytic Fungi from Schinus terebinthifolius. Curr. Microbiol. 2016, 72, 173–183. [Google Scholar] [CrossRef] [PubMed]
- Chagas, M.B.D.O.; Dos Santos, I.P.; Da Silva, L.C.N.; Correia, M.T.D.S.; De Araújo, J.M.; Cavalcanti, M.D.S.; Lima, V. Antimicrobial Activity of Cultivable Endophytic Fungi Associated with Hancornia speciosa Gomes Bark. Open Microbiol. J. 2017, 11, 179–188. [Google Scholar] [CrossRef] [PubMed]
- Lima Neto, G.A.; Kaffashi, S.; Luiz, W.T.; Ferreira, W.R.; Dias Da Silva, Y.S.A.; Pazin, G.V.; Violante, I.M.P. Quantificação de Metabólitos Secundários e Avaliação Da Atividade Antimicrobiana e Antioxidante de Algumas Plantas Selecionadas Do Cerrado de Mato Grosso. Rev. Bras. Plantas Med. 2015, 17, 1069–1077. [Google Scholar] [CrossRef]
- Machado, A.D.O.; Silva, A.P.; Consolaro, H.; Barros, M.A.G.; Oliveira, P.E. Breeding Biology and Distyly in Palicourea rigida H. B. & K. (Rubiaceae) in the Cerrados of Central Brazil. Acta Bot. Bras. 2010, 24, 686–696. [Google Scholar] [CrossRef]
- Jia, M.; Chen, L.; Xin, H.-L.; Zheng, C.-J.; Rahman, K.; Han, T.; Qin, L.-P. A Friendly Relationship between Endophytic Fungi and Medicinal Plants: A Systematic Review. Front. Microbiol. 2016, 7, 906. [Google Scholar] [CrossRef] [PubMed]
- Notarte, K.I.R.; Devanadera, M.K.P.; Mayor, A.B.R.; Cada, M.C.A.; Pecundo, M.H.; Macabeo, A.P.G. Toxicity, Antibacterial, and Antioxidant Activities of Fungal Endophytes Colletotrichum and Nigrospora spp. Isolated from Uvaria grandiflora. Philipp. J. Sci. 2019, 148, 503–510. [Google Scholar]
- Mahmud, S.M.N.; Sohrab, M.H.; Begum, M.N.; Rony, S.R.; Sharmin, S.; Moni, F.; Akhter, S.; Mohiuddin, A.K.M.; Afroz, F. Cytotoxicity, Antioxidant, Antimicrobial Studies and Phytochemical Screening of Endophytic Fungi Isolated from Justicia gendarussa. Ann. Agric. Sci. 2020, 65, 225–232. [Google Scholar] [CrossRef]
- Slippers, B.; Boissin, E.; Phillips, A.J.L.; Groenewald, J.Z.; Lombard, L.; Wingfield, M.J.; Postma, A.; Burgess, T.; Crous, P.W. Phylogenetic Lineages in the Botryosphaeriales: A Systematic and Evolutionary Framework. Stud. Mycol. 2013, 76, 31–49. [Google Scholar] [CrossRef] [PubMed]
- Slippers, B.; Roux, J.; Wingfield, M.J.; van der Walt, F.J.J.; Jami, F.; Mehl, J.W.M.; Marais, G.J. Confronting the Constraints of Morphological Taxonomy in the Botryosphaeriales. Pers. Mol. Phylogeny Evol. Fungi 2014, 33, 155–168. [Google Scholar] [CrossRef]
- Duan, X.; Xu, F.; Qin, D.; Gao, T.; Shen, W.; Zuo, S.; Yu, B.; Xu, J.; Peng, Y.; Dong, J. Diversity and Bioactivities of Fungal Endophytes from Distylium chinense, a Rare Waterlogging Tolerant Plant Endemic to the Three Gorges Reservoir. BMC Microbiol. 2019, 19, 278. [Google Scholar] [CrossRef] [PubMed]
- Do Nascimento, A.M.; Soares, M.G.; da Silva Torchelsen, F.K.V.; de Araujo, J.A.V.; Lage, P.S.; Duarte, M.C.; Andrade, P.H.R.; Ribeiro, T.G.; Coelho, E.A.F.; do Nascimento, A.M. Antileishmanial Activity of Compounds Produced by Endophytic Fungi Derived from Medicinal Plant Vernonia polyanthes and Their Potential as Source of Bioactive Substances. World J. Microbiol. Biotechnol. 2015, 31, 1793–1800. [Google Scholar] [CrossRef]
- Faria, P.C.S.; Senabio, J.; Soares, M.; Silva, F.G.; Cunha, A.P.; Souchie, E.L. Assessment of Functional Traits in the Assemblage of Endophytic Fungi of Anacardium othonianum Rizzini. Pak. J. Bot. 2016, 48, 1241–1252. [Google Scholar]
- Gomes, R.R.; Glienke, C.; Videira, S.I.R.; Lombard, L.; Groenewald, J.Z.; Crous, P.W. Diaporthe: A Genus of Endophytic, Saprobic and Plant Pathogenic Fungi. Pers. Mol. Phylogeny Evol. Fungi 2013, 31, 1–41. [Google Scholar] [CrossRef] [PubMed]
- Noriler, S.A.; Savi, D.C.; Aluizio, R.; Palácio-Cortes, A.M.; Possiede, Y.M.; Glienke, C. Bioprospecting and Structure of Fungal Endophyte Communities Found in the Brazilian Biomes, Pantanal, and Cerrado. Front. Microbiol. 2018, 9, 1526. [Google Scholar] [CrossRef]
- Sunkar, S.; Sibitha, V.; Nachiyar, V.; Pandurangan, P.; Renugadevi, K. Bioprospecting Endophytic Fungus Colletotrichum sp. Isolated from Artocarpus heterophyllus for Anticancer Activity. Res. J. Biotechnol. 2017, 12, 46–56. [Google Scholar]
- Krishnamurthy, Y.L.; Naik, B.S. Endophytic Fungi Bioremediation. In Endophytes: Crop Productivity and Protection; Maheshwari, D.K., Annapurna, K., Eds.; Springer International Publishing: Cham, Switzerland, 2017; Volume 16, pp. 47–60. ISBN 978-3-319-66543-6. [Google Scholar]
- Russell, J.R.; Huang, J.; Anand, P.; Kucera, K.; Sandoval, A.G.; Dantzler, K.W.; Hickman, D.; Jee, J.; Kimovec, F.M.; Koppstein, D.; et al. Biodegradation of Polyester Polyurethane by Endophytic Fungi. Appl. Environ. Microbiol. 2011, 77, 6076–6084. [Google Scholar] [CrossRef]
- Adnan, M.; Alshammari, E.; Ashraf, S.A.; Patel, K.; Lad, K.; Patel, M. Physiological and Molecular Characterization of Biosurfactant Producing Endophytic Fungi Xylaria regalis from the Cones of Thuja plicata as a Potent Plant Growth Promoter with Its Potential Application. BioMed Res. Int. 2018, 2018, 7362148. [Google Scholar] [CrossRef] [PubMed]
- Hiltunen, S.; Mankinen, A.; Javed, M.A.; Ahola, S.; Venäläinen, M.; Telkki, V.-V. Characterization of the Decay Process of Scots Pine Caused by Coniophora puteana Using NMR and MRI. Holzforschung 2020, 74, 1021–1032. [Google Scholar] [CrossRef]

| Fungal Extract | Total Solids Content (%) | Concentration of Fungal Extract Used in Assays (mg mL−1) | |||
|---|---|---|---|---|---|
| Concentration 1 | Concentration 2 | Concentration 3 | Concentration 4 | ||
| SXS649 | 0.97 | 9.70 | 4.85 | 2.42 | 1.21 |
| SXS650 | 2.52 | 25.20 | 12.60 | 6.30 | 3.15 |
| SXS651 | 2.32 | 23.20 | 11.60 | 5.80 | 2.90 |
| SXS652 | 2.70 | 27.00 | 13.50 | 6.75 | 3.37 |
| Fungal Extract | Phenolics (mg of Gallic Acid/1 mL) | Flavonoids (mg of Rutin/1 mL) |
|---|---|---|
| SXS649 | 890 ± 12.50 | 374 ± 3.00 |
| SXS650 | 322 ± 6.55 | 185 ± 1.73 |
| SXS651 | 233 ± 6.02 | 84 ± 2.30 |
| SXS652 | 210 ± 4.61 | 159 ± 1.52 |
| Fungal Extract | IC50 DPPH * | AA% ** | IC50 FRAP *** | Concentration to Achieve IC50 (mg mL−1) **** |
|---|---|---|---|---|
| SXS649 | 5.6804 ± 0.38 | 57.8529 | 8.0917 ± 0.03 | 4.85 |
| SXS650 | 22.4748 ± 1.20 | 51.2709 | 47.0602 ± 0.03 | 25.20 |
| SXS651 | 11.8528 ± 1.06 | 65.4832 | 0.00 | 11.60 |
| SXS652 | 27.4803 ± 0.00 | 46.3043 | 32.2691 ± 0.25 | 27.00 |
| Control (BHT) | 0.0118 ± 0.00 | 65.5431 | - | 0.01 |
| Sample Concentrations | Germination (%) (n = 240) * | Average Length of Root (mm2) | Average Length of the Hypocotyl (mm2) |
|---|---|---|---|
| 100 g of soil + 32 mL of water (Control 1) | 95.00 ± 5.00 a | 23.47 ± 2.12 a | 41.38 ± 5.47 a |
| 100 g of soil + 10% soy oil (Control 2) | 40.00 ± 7.07 c | 10.38 ± 2.56 b | 18.66 ± 5.35 b |
| 100 g of soil + 10% soy oil + 32 mL of SXS649 fungal extract | 72.50 ± 4.33 b | 21.36 ± 0.81 a | 35.90 ± 1.67 a |
| 100 g of soil + 10% soy oil + 32 mL of SXS650 fungal extract | 67.50 ± 4.33 b | 20.86 ± 2.96 a | 34.49 ± 4.63 a |
| 100 g of soil + 10% soy oil + 32 mL of SXS651 fungal extract | 65.00 ± 5.00 b | 20.94 ± 1.64 a | 36.62 ± 1.19 a |
| 100 g of soil + 10% soy oil + 32 mL of SXS652 fungal extract | 60.00 ± 0.00 b | 22.87 ± 0.91 a | 35.83 ± 4.12 a |
| Fungal Taxa | A. niger | Inhibition (%) I. rickii | P. mangiferae | C. puteana |
|---|---|---|---|---|
| SXS649 | 56.79 ± 0.89 a | 50.00 ± 0.51 c | 53.16 ± 1.24 b | 42.85 ± 1.22 b |
| (B) | (A) | (A) | (A) | |
| SXS650 | 59.25 ± 3.60 a | 57.14 ± 1.06 a | 48.10 ± 0.66 c | 36.73 ± 1.08 c |
| (B) | (A) | (A) | (B) | |
| SXS651 | 54.32 ± 0.87 a | 47.14 ± 1.25 d | 56.96 ± 0.69 a | 38.77 ± 0.89 c |
| (A) | (A) | (CA1) | (CA1) | |
| SXS652 | 50.61 ± 0.87 b | 54.28 ± 1.13 b | 34.17 ± 0.81 d | 76.93 ± 0.81 a |
| (B) | (A) | (A) | (CA1) |
| Fungal Extract | CL50 (mg mL−1) | Break (95% Confidence) | Degree of Toxicity at All Concentrations of Fungal Extract |
|---|---|---|---|
| SXS649 | 5.00 | 4.47 ± 5.53 | strong |
| SXS650 | 12.51 | 10.25 ± 14.77 | strong |
| SXS651 | 16.46 | 15.14 ± 17.77 | strong |
| SXS652 | 13.23 | 10.73 ± 15.73 | strong |
| Control (Potassium dichromate) | 0.046 | 0.041 ± 0.51 | strong |
Publisher’s Note: MDPI stays neutral with regard to jurisdictional claims in published maps and institutional affiliations. |
© 2021 by the authors. Licensee MDPI, Basel, Switzerland. This article is an open access article distributed under the terms and conditions of the Creative Commons Attribution (CC BY) license (https://creativecommons.org/licenses/by/4.0/).
Share and Cite
dos Santos, I.R.; Abdel-Azeem, A.M.; Mohesien, M.T.; Piekutowska, M.; Sheir, D.H.; da Silva, L.L.; da Silva Castro, C.; Carvalho, D.D.C.; Bezerra, J.D.P.; Saad, H.A.; et al. Insights into the Bioprospecting of the Endophytic Fungi of the Medicinal Plant Palicourea rigida Kunth (Rubiaceae): Detailed Biological Activities. J. Fungi 2021, 7, 689. https://doi.org/10.3390/jof7090689
dos Santos IR, Abdel-Azeem AM, Mohesien MT, Piekutowska M, Sheir DH, da Silva LL, da Silva Castro C, Carvalho DDC, Bezerra JDP, Saad HA, et al. Insights into the Bioprospecting of the Endophytic Fungi of the Medicinal Plant Palicourea rigida Kunth (Rubiaceae): Detailed Biological Activities. Journal of Fungi. 2021; 7(9):689. https://doi.org/10.3390/jof7090689
Chicago/Turabian Styledos Santos, Igor Romeiro, Ahmed M. Abdel-Azeem, Marwa T. Mohesien, Magdalena Piekutowska, Donia H. Sheir, Lucas Leonardo da Silva, Camila da Silva Castro, Daniel Diego Costa Carvalho, Jadson Diogo Pereira Bezerra, Hosam A. Saad, and et al. 2021. "Insights into the Bioprospecting of the Endophytic Fungi of the Medicinal Plant Palicourea rigida Kunth (Rubiaceae): Detailed Biological Activities" Journal of Fungi 7, no. 9: 689. https://doi.org/10.3390/jof7090689
APA Styledos Santos, I. R., Abdel-Azeem, A. M., Mohesien, M. T., Piekutowska, M., Sheir, D. H., da Silva, L. L., da Silva Castro, C., Carvalho, D. D. C., Bezerra, J. D. P., Saad, H. A., Borges, L. L., & Xavier-Santos, S. (2021). Insights into the Bioprospecting of the Endophytic Fungi of the Medicinal Plant Palicourea rigida Kunth (Rubiaceae): Detailed Biological Activities. Journal of Fungi, 7(9), 689. https://doi.org/10.3390/jof7090689

